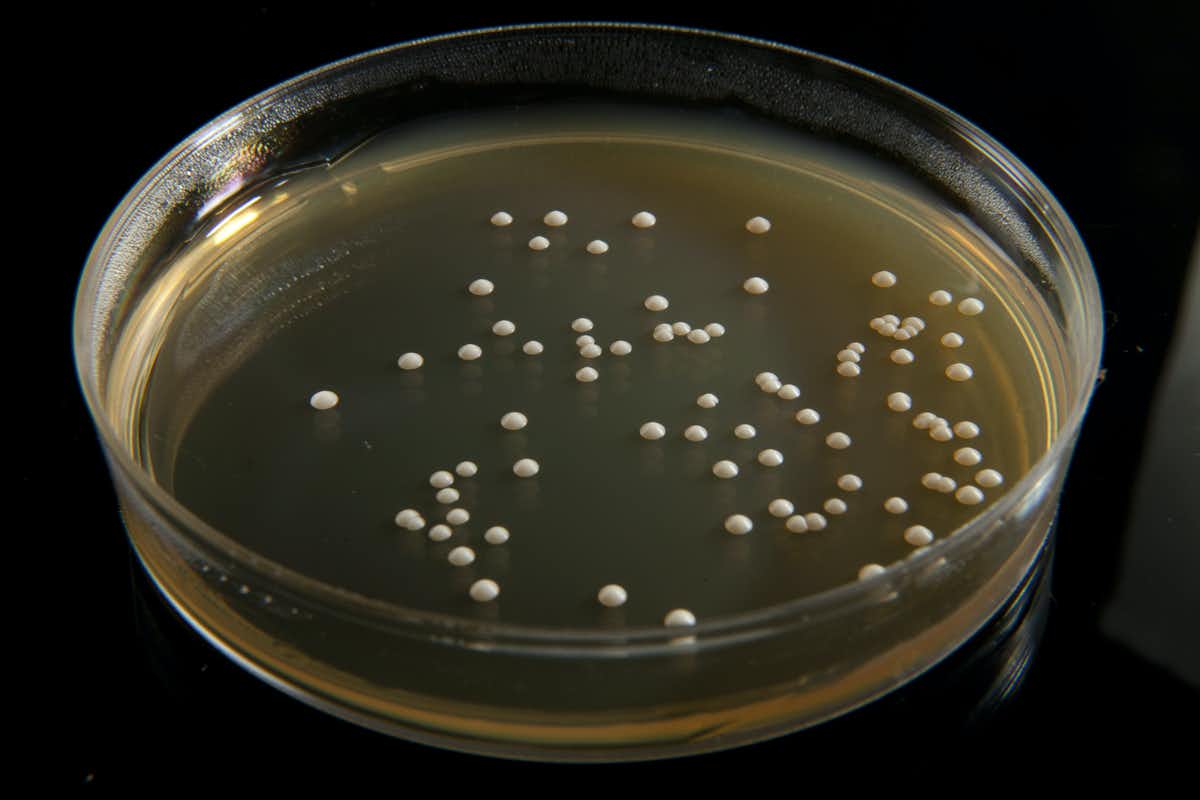
نقش بسیار پررنگ هوش مصنوعی در پزشکی و داروسازی

فناوری های یاد گیری ماشین در همه جا وجود دارد. از آنها توسط موتورهای جستجو، رسانه های اجتماعی و حتی در بانکداری آنلاین استفاده می شود. اما یکی از زمینه هایی که این فناوری همچنان در آن در حال ظهور و نو آری است، پزشکی است.
فناوری های یاد گیری ماشین می تواند در پزشکی بسیار امیدوار کننده باشد و می تواند برای بسیاری از برنامه ها مانند تشخیص علائم بیماری در سلول ها یا کشف داروهای جدید برای بیماری های نادر مورد استفاده قرار گیرد. اما برای این که یک رویکرد یاد گیری ماشین بتواند چنین کارهایی را انجام دهد، باید هم دقیق باشد و هم بتواند نحوه کار سلول ها را درک نماید.
تیم ما رویکرد دقیقی از یاد گیری ماشین را ایجاد کرده است که می تواند رشد سلول را به گونه ای پیش بینی کند که محققان به راحتی قادر به درک آن باشند. تکنیک یاد گیری ماشین با مشاهده چگونگی تغییر و عملکرد سلول ها در شرایط مختلف، پیش بینی های خود را انجام می دهد. این روش می تواند روزی برای تشخیص سرطان یا پیش بینی نحوه تعامل برخی داروها با بیمار مورد استفاده قرار گیرد.
تفسیر پیش بینی های یاد گیری ماشین
در واقع، یاد گیری ماشین نوعی هوش مصنوعی (AI) است که در آن از داده ها برای یاد گیری رایانه تا رسیدن به تصمیم گیری به تنهایی استفاده می شود، بدون این که شخصی نیاز به حضور در آن جا داشته باشد تا این کار را برای رایانه انجام دهد.اما یکی از نقاط ضعف اصلی تکنیک های یاد گیری ماشین در زیست شناسی و پزشکی این واقعیت است که آنها از دانش بیولوژیکی - مانند بیوشیمی سلولی زمینه ای - در فرآیند یاد گیری استفاده نمی کنند. به طور کلی، آنها همچنین هنگام پیش بینی خود این دانش را نادیده می گیرند. این بدان دلیل است که این سیستم ها اصولاً با اطلاعات بیولوژیکی به عنوان داده یا اعداد برخورد می کنند، و بنابراین معنای واقعی بیولوژیکی این اعداد را در نظر نمی گیرند.
از چنین سیستم هایی غالباً به عنوان سیستم های "جعبه سیاه" یاد می شود. این ها هوش مصنوعیای هستند که از داده ها تغذیه می شوند و بر اساس الگوهای یافت شده در آن داده ها، تصمیم یا پیش بینی روشنی را در اختیار کاربران قرار می دهند. با این حال، به دلیل پیچیده بودن تحلیل، معمولاً مشخص نیست که هوش مصنوعی چگونه تصمیم خود را گرفته است.
دولت باید یک تضمین مطلق برای عدم به اشتراک گذاری اطلاعات بیمار در خارج از سیستم های بهداشتی، درمانی و پژوهشی ارائه دهد. درک چگونگی پیش بینی جعبه سیاه در زمینه هایی که تنها وجود دقت زیاد در نتیجه، مهمترین هدف است موضوعی حائز اهمیت نیست - مانند نرم افزارهای مورد استفاده برای پیش بینی ایمیل های هرزنامه. اما این امر یک اشکال عمده در پزشکی، که در آن لازم است همه مسیرهای رسیدن به نتیجه شفاف باشد، محسوب می شود. پیش بینی های جعبه سیاه به دلیل پیچیده بودن آنها توسط محققان قابل تفسیر نیستند، به این معنی که آنها درک کمی از نحوه رسیدن الگوریتم AI به پیش بینیاش دارند.
از طرف دیگر، سیستم های "جعبه سفید" می توانند در تصمیم گیری ها یا پیش بینی های خود کمی کمتر دقیق باشند، اما در عوض روابطی که بر اساس داده های داده شده استنباط کرده اند برای کاربران روشن تر است. مزیت سیستم های جعبه سفید این است که کاربران می توانند درک کنند که سیستم از چه اطلاعاتی برای پیش بینی خود استفاده می کند و از آن جا که این قابل فهم است، کاربران همچنین می توانند خود تصمیم را استیضاح کنند و از نظر بیولوژیکی تفسیر نمایند.
پیش بینی های یاد گیری ماشین برای قابل اعتماد بودن و کار در پزشکی باید قابل تفسیر و توجیه باشند. در مورد تشخیص سرطان، اگر روش AI پیش بینی مثبت کاذب انجام دهد، می تواند منجر به درمان غیر ضروری شود - در حالی که پیش بینی های منفی کاذب می تواند منجر به درمان نشدن بیماری شود. درک چگونگی پیش بینی های انجام شده توسط الگوریتم های یاد گیری ماشین همچنین به شما در جلو گیری از رسیدن به نتیجه منفی کاذب هنگام تحقیق در باره داروهای بالقوه و هرگونه عوارض جانبی آنها کمک می کند.
پیش بینی رشد سلول
برای این که روش های هوش مصنوعی در پزشکی زیستی کار کنند، ابتدا لازم است یک روش یاد گیری ماشین را طراحی کنیم که بتواند رشد سلول را پیش بینی کند و بفهمد چه چیزی باعث این رشد می شود. درک چگونگی رشد سلول ها و تغییر رشد آنها در شرایط مختلف، اولین قدم برای طراحی یک هوش مصنوعی است که بتواند وجود بیماری را تشخیص دهد یا پیش بینی کند که درمان های خاص چگونه کار می کنند.تیم ما 27 روش یاد گیری ماشین مختلف را ارزیابی کرد که به هر دو پروفایل بیان ژن و مدل های متابولیکی مکانیکی نظر داشتند. پروفایل های بیان ژن نشان می دهند که روند جمع آوری پروتئین سلول در شرایط مختلف چگونه تغییر می کند. مدل های متابولیکی نشان می دهند که بیوشیمی سلولی زمینه ای در هر سویه چگونه کار می کند.
سپس ما تکنیک یاد گیری ماشین جعبه سفید خود را ساختیم، که به ما امکان می دهد به راحتی چگونگی تصمیم گیری هوش مصنوعی، و غلبه بر کاستی های قبلی روش های یاد گیری کامپیوتر را تفسیر کنیم. ما این کار را با آموزش هوش مصنوعی خود برای تصمیم گیری با استفاده از داده های بیان ژن و مدل های متابولیکی انجام دادیم - کاری که قبلاً انجام نشده بود.
فناوری های یاد گیری ماشین می تواند در پزشکی بسیار امیدوار کننده باشد و می تواند برای بسیاری از برنامه ها مانند تشخیص علائم بیماری در سلول ها یا کشف داروهای جدید برای بیماری های نادر مورد استفاده قرار گیرد. استفاده از هر دو مدل برای ایجاد رویکرد یاد گیری ماشین ما، دقت پیش بینی را در مقایسه با استفاده از فقط داده های بیان ژن، در برخی موارد تا 4٪ بهبود بخشید. این دارای این مزیت است که فعل و انفعالات قبلاً ناشناخته بین بیان ژن و فعالیت متابولیکی را نشان می دهد.
تصویر: یک ظرف پتری از مخمر Saccharomyces cerevisiae که در آزمایشگاه رشد کرده است.
استفاده از این نوع مخمر در پخت و پز معمول است. sruilk / Shutterstock
سپس رویکرد خود را در بیش از 1000 سویه مختلف از Saccharomyces cerevisiae، گونه ای از مخمر که در پختن، دم کردن، و ماء الشیر سازی معمول است، بررسی کردیم. داده های مربوط به این نوع مخمرها به طور گسترده در دسترس است، و این امر، ارزیابیِ کارایی روش یاد گیری ماشین ما را آسان می سازد.
نتایج حاصل از مخمر نشان داد که با پیگیری رویکرد جعبه سفید می توانیم دقت پیش بینی تکنیک های هوش مصنوعی را حفظ کرده و در برخی موارد همچنین بهبود ببخشیم. اما مهمتر از همه این است که ما همچنین با توضیح این که واکنش بیوشیمیایی در سلول در شرایط مختلف فعال است، تفسیری از این پیش بینی ها ارائه می دهیم.
رویکرد ما شامل استفاده از اطلاعات مکانیسم های بیولوژیکی، مانند بیوشیمی سلولی، در فرایند یاد گیری است. این امر بر محدودیت های جعبه سیاه در رویکردهای متداول داده محور غلبه می کند و گامی است رو به جلو به سمت توسعه مدل های تفسیری یاد گیری ماشین.
داده ها برای هوش مصنوعی به اندازه ذغال سنگ برای راه آهن و سوخت برای اتومبیل رانی حیاتی هستند.مزیت این امر این است که مدل های یاد گیری ماشین بر اساس رویکرد ما قابل اعتمادتر خواهند بود. نتایج ما نشان می دهد که ترکیب داده ها و مدل های دانش محور، اطلاعات بیشتری در مورد چگونگی رشد و کار سلول ها در شرایط خاص به محققان می دهد.
گر چه این سیستم هنوز هم باید با استفاده از سلول های انسانی آزمایش شود، اما در آینده می تواند برنامه های امیدوار کننده زیادی داشته باشد. به عنوان مثال، درک این که سلول های سرطانی تحت تأثیر ژنتیک و شرایط محیطی قرار می گیرند، یک چالش اساسی در درمان بیماری و پیشگیری از آن است.
نقش انقلابی هوش مصنوعی در پزشکی با اشتراک داده ها

تصویر: وجود داده های ناشناس برای کار با هوش مصنوعی بسیار مهم است. alphaspirit / Shutterstock
معمولاً این گونه نیست که یک فرد شاهد پیشرفتی انقلابی و تحول آفرین در پزشکی در طول عمر خود باشد. اما استفاده از هوش مصنوعی (AI) برای بهبود تشخیص زود رسِ بیماری، دقیقاً پیشرفتی از همین نوع است.
ما از نویسندگان مقاله ای بودیم که اخیراً در نیچر منتشر شد و نشان داد که یک سیستم هوش مصنوعی ساخته شده توسط گوگل در تشخیص تومور پستان بهتر از پزشکان عمل می کند. اکنون، محققان در ایالات متحده گزارش داده اند که اسکنرهای لیزری پشتیبانی شده توسط هوش مصنوعی در تشخیص تومورهای مغزی سریع تر از پزشکان هستند. این ها تحولات بسیار مهیجی هستند که در نهایت تأثیر زیادی در دقت، تدارکات و سرعت تشخیص خواهند داشت.
بسیاری از پروژه های مشابه در حال انجام است که در آنها از هوش مصنوعی در تشخیص زود رس تخریب ماکولا، نارسایی حاد کلیه، سرطان پوست، سپسیس، بیماری آلزایمر و افسردگی و غیره استفاده می شود.
بهداشت و درمان به ویژه سرزمین حاصلخیز این پیشرفت ها را فراهم می کند زیرا حجم و پیچیدگی دانش پزشکی بسیار زیاد است. هیچ پزشک بالینی، هرچند باهوش، امیدوار به تسلط بر آن نیست. (حداقل هنوز) هدف این نیست که وجود پزشک با این سیستم جایگزین شود بلکه لازم است تخصص پزشکی وی را با این سیستم افزایش دهیم.
نجات جان، و صرفه جویی در هزینه ها
بر اساس برخی تخمین ها، علاوه بر تسریع در تشخیص و دقیق تر کردن آن، صرفاً در بخش مراقبت های بهداشتیِ ایالات متحده، حدود 400 میلیارد دلار صرفه جویی بالقوه ممکن است با این پیشرفت ها صورت گیرد.اسکنرهای لیزری پشتیبانی شده توسط هوش مصنوعی در تشخیص تومورهای مغزی سریع تر از پزشکان هستند. برای دستیابی به این هدف، دانشمندان نیاز به دسترسی به داده ها دارند. داده ها برای هوش مصنوعی به اندازه ذغال سنگ برای راه آهن و سوخت برای اتومبیل رانی حیاتی هستند. اتا پیسانو، مدیر ارشد تحقیقات کالج رادیولوژی آمریکا، در تفسیری که در کنار مقاله ما در Nature منتشر شده است، می گوید برای تحقق نوید استفاده از AI در مراقبت های بهداشتی، داده های پزشکی برای سلامتی ما باید ارزشی همچون آب آشامیدنی داشته باشد.
.jpg)
تصویر: وقتی داده های پزشکی، همچون آب ارزشمند است. Sebra / Shutterstock
این یک تصویر قابل توجه است: سوابق پزشکی جهانی ما ممکن است به اندازه آبی که می نوشیم و هوایی که تنفس می کنیم برای سلامتی ما حیاتی باشند. و همان طور که ما به دنبال محافظت از آب آشامیدنی خود در برابر آلودگی و نگران مسأله آلودگی هوا هستیم، باید از سوابق خود در برابر سوء استفاده محافظت کنیم. عنوان محقق، می دانیم که خطر واقعی هنگام محرمانه نگه داشتن سوابق بیمار است. و، به عنوان بیمار، می دانیم که ایمنی داده های ما مهمترین مسأله است.
برای تحقیق مان در مورد قابلیت هوش مصنوعی در تشخیص سرطان پستان، ما بیش از 29000 ماموگرافی از زنان در انگلیس و ایالات متحده را مطالعه کردیم. تمام سوابق ناشناس بودند و هیچ زنی قابل شناسایی نبود – که روشی استاندارد برای محافظت از اطلاعات خصوصی بیمار است. اما تحقیق بدون دستیابی به این داده های حیاتی نمی توانست پیش برود.
پیش بینی های یاد گیری ماشین برای قابل اعتماد بودن و کار در پزشکی باید قابل تفسیر و توجیه باشند. اگر خواهان رشدی هستیم که این نوآوری ها می توانند باعث شوند، باید نشان دهیم که چرا به اشتراک گذاری داده ها یک مزیت اجتماعی است. ضرورتی اخلاقی برای بهبود مراقبت از دیگران در جریان تحقیق وجود دارد. بزرگترین چالش، ایجاد یک سیستم حاکم بر داده ها است که از منافع بیماران محافظت کند، دسترسی محققان را فراهم آورد، ثمرات موفقیت را به طور عادلانه توزیع کند و اعتماد عمومی را جلب نماید.
همان طور که در استراتژی صنعتی 2017 خود ذکر کرده است، دولت انگلیس یک شورای هوش مصنوعی برای تقویت رشد هوش مصنوعی در انگلیس و استفاده اخلاقی از آن و یک مرکز برای اخلاق داده ها برای ایجاد یک رژیم حاکم بر فناوری های مبتنی بر داده ایجاد کرده است. این یک درک مهم از اهمیت اصلی اتخاذ یک رویکرد اخلاقی برای توسعه این فناوری هاست.
اما باید بیشتر پیش برویم. اعتماد عمومی خواستار شفافیت بیشتر و ایجاد مشوق هایی برای اجازه داده شدن بیشتر به اشتراک گذاری داده ها است - به عنوان مثال، با دادن سهمی از هرگونه سود تجاری حاصل از استفاده از داده های NHS به NHS. همچنین لازم است یک منشور داده مخصوص سلامت وجود داشته باشد، با قوانین، هنجارها و استانداردهای روشن، که مشخص کند چه کاری می تواند انجام شود، چه کاری باید انجام شود و چه کاری ممکن است انجام نشود. دولت باید یک تضمین مطلق برای عدم به اشتراک گذاری اطلاعات بیمار در خارج از سیستم های بهداشتی، درمانی و پژوهشی ارائه دهد. استفاده کنندگان از داده های NHS باید اثبات کنند که از آنها برای بهبود کیفیت، ایمنی و کارایی استفاده می کنند.
یاد گیری ماشین نوعی هوش مصنوعی (AI) است که در آن از داده ها برای یاد گیری رایانه تا رسیدن به تصمیم گیری به تنهایی استفاده می شود، بدون این که شخصی نیاز به حضور در آن جا داشته باشد تا این کار را برای رایانه انجام دهد.در این فناوری ها فرصت های زیادی برای پیشرفت مراقبت های بهداشتی، بهره مندی از سیستم های بهداشتی و چشم انداز بهبود میلیون ها بیمار وجود دارد. اما مگر این که از همان ابتدا قوانین روشنی وضع کنیم، در معرض به خطر افتادن اعتماد عمومی، تسلیم دستاوردهای کلینیکی حیاتی و به هدر رفتن پتانسیل مقادیر زیادی از داده های پزشکی هستیم که دهه ها برای جمع آوری آنها وقت صرف کرده ایم.
منبع: کلودیو اَنجیون، آرا درزی، Imperial College London، Teesside University





























